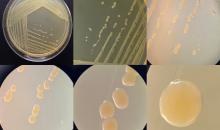

Curtobacterium flaccumfaciens pv. betae(CORBBE)
Overview
Code created in: 2002-03-11
Basic information
- EPPO Code:
CORBBE
- Preferred name:
Curtobacterium flaccumfaciens pv. betae
- Authority:
(Keyworth, Howell & Dowson) Collins & Jones
Other scientific names
| Name |
Authority |
| Corynebacterium betae |
Keyworth, Howell & Dowson |
| Corynebacterium flaccumfaciens pv. betae |
(Keyworth, Howell & Dowson) Dye & Kemp |
Common names
| Name |
Language |
| bacterial wilt of red beet |
English |
| silvering disease of red beet |
English |
| Silberblattkrankheit: Rote Rübe |
German |
| gale argentée de la betterave rouge |
French |
| sarna plateada de la remolacha roja |
Spanish |